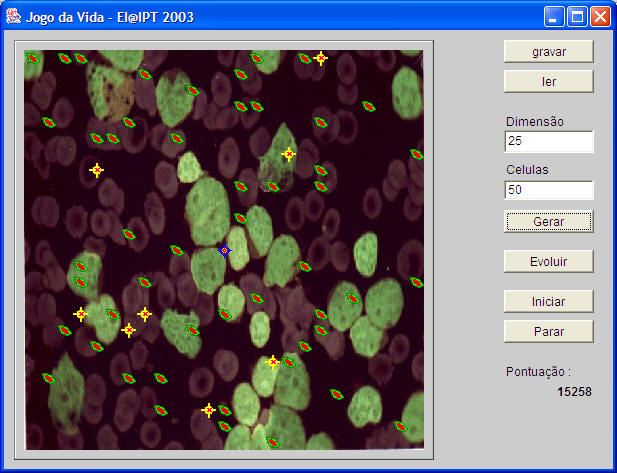

|
|||||||||
| PREV NEXT | FRAMES NO FRAMES | ||||||||
!!! deverá destruir os virus
e manter a evolução dos grupos de celulas
, atraves da introdução de novas celulas
e armazenar o maior número de pontos (1 por cada celula viva em cada evolução) até que o universo se extinga
|
|||||||||
| PREV NEXT | FRAMES NO FRAMES | ||||||||